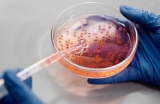
Tout savoir sur l‘éventuel lien entre l’hélicobacter pylori et la prise de poids

Latest Posts
La nature recèle de nombreuses richesses pour l’humanité. Pour cause de leur utilité, les recherches portant sur ces précieuses ressources sont sans fin. L’un ...
Pour baisser le taux de cholestérol dans le sang, plusieurs solutions sont proposées, dont le traitement avec les statines. Ce sont des médicaments ...
Pour être en forme et en bonne santé, nombreuses sont les molécules et minéraux qui agissent. Parmi les minéraux, le magnésium est d'une grande importance et ...
Le corps humain héberge de nombreuses bactéries dont certaines représentent un danger sur le court terme ou sur le long terme. Parmi ces bactéries néfastes, on ...
La cruralgie est une affection douloureuse qui touche les adultes ayant plus de 50 ans. Lorsque vous en souffrez, elle vous met dans une situation très ...
En passant la main derrière l’oreille, il est possible de ressentir la présence d’un ganglion. Une petite boule qui peut dans bien des cas entraîner des ...
On désigne par glycémie par mmol, le taux de sucre au millimol par litre dans le liquide sanguin. Si elle excède, le risque de développer l’hyperglycémie est ...
Les douleurs sous côte gauche irradiant le dos peuvent parfois être gênantes. Pire, elles peuvent cacher des maladies silencieuses graves. Voici les ...
Avez-vous déjà eu le ventre qui gargouille ? Faites-vous des selles jaunes ? Si c’est le cas, sachez que vous n’êtes pas anormal. Ce sont des manières pour le ...
La créatinine urinaire élevée est le taux exagéré de la créatinine dans l’urine. C’est une substance métabolique synthétisée par le foie et conservée dans les ...